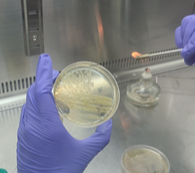

벤젠은 휘발성유기화합물(Volatile Organic Compounds, VOCs)의 일종으로 대기 중으로 쉽게 증발하여 광화학 반응을 통해 미세먼지 및 오존 발생의 주요 원인이 되기도 하며, 세계보건기구(WHO) 산하의 국제암연구소(IRAC)에서 1군 발암물질로도 지정되어 있다.
식물내생미생물은 식물체 내에 존재하는 세균, 고세균, 곰팡이 등 다양한 미생물을 의미하며, 이들은 식물의 생장 및 발달뿐만 아니라, 오염물질을 분해하는 기능도 가진 것으로 알려져 있다.
국립산림과학원 연구진은 이에 착안하여 산업단지 및 군사지역 등에서 자생하고 있는 식물로부터 식물내생미생물을 분리하고 이들 가운데 벤젠 저감능을 가진 식물내생미생물을 발굴하기 위한 연구를 추진했다. 2년에 걸쳐 전국 21개소, 94개의 식물로부터 식물내생미생물을 분리했으며, 이들 중 3 균주가 벤젠 저감 능력이 있는 것을 확인했다.
발굴된 벤젠 저감 기능성 식물내생미생물을 생장이 우수한 나무에 접종하고 벤젠으로 오염된 산업단지 및 군사지역에 식재하여 오염지의 토양과 공기를 정화하는 데 활용할 계획이다.
임목자원연구과 이일환 박사는 “최근 미세먼지 등 환경 오염물질에 대한 국민적 우려가 커짐에 따라 이들에 대한 저감능이 우수한 나무의 육성 및 식재에 대한 사회·정책적 수요가 증가하고 있는데, 발굴된 산림내생미생물을 통해 이를 해결할 수 있도록 노력하겠다.”라고 밝혔다.
<저작권자 ⓒ 더뉴스프라임, 무단 전재 및 재배포 금지>
박현아 기자 다른기사보기
